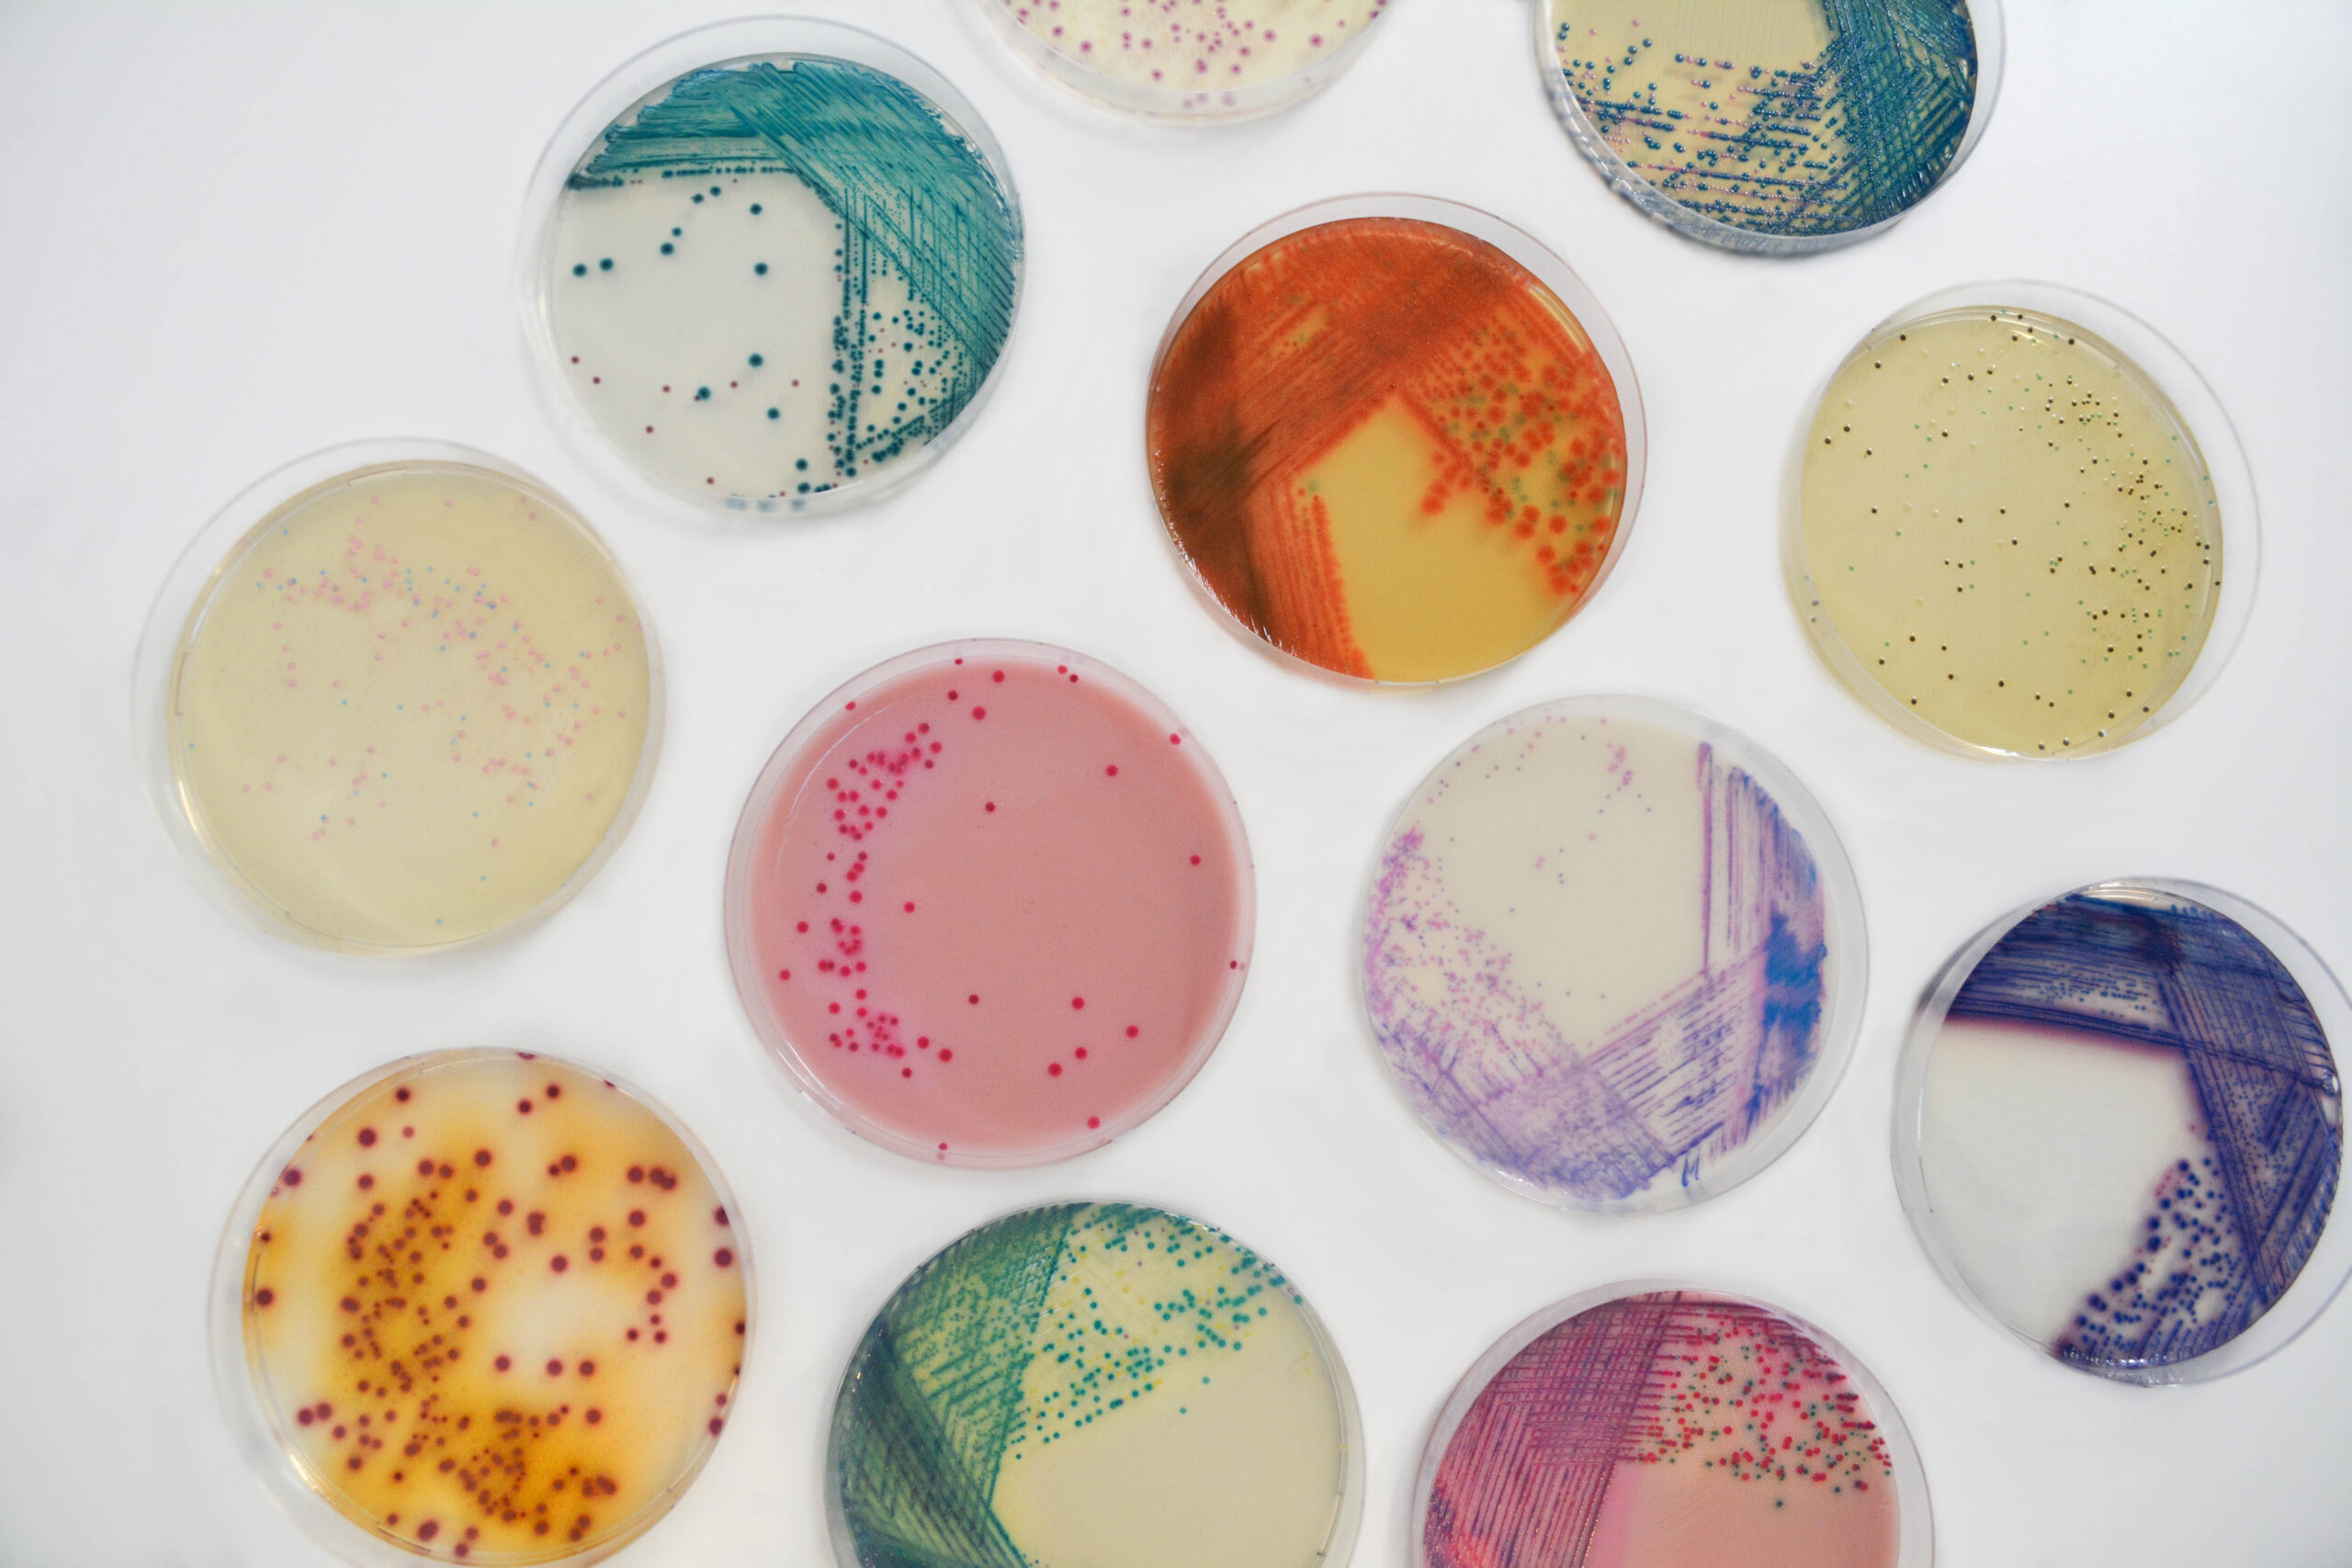
About

Total Products
Total Clients
Petria Life Science is a trusted and leading life science manufacturing and trading company dedicated to driving advancements in the field of life sciences with a deep understanding of the industry and a commitment to excellence, we empower businesses and researchers to access cutting-edge products, equipment, and services efficiently and effectively.
Discover More
Copyright ©2026 Petria Life Science. Designed By CuteWeb